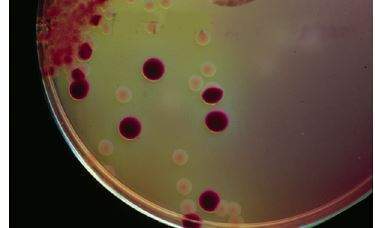

신우염 초기증상
기침은 폐암의 초기 증상 중 가장 흔하며 많게는 폐암 환자의 75가 잦은 기침을 호소합니다. 간혹 옆구리에 통증이 느껴지고 고열이 나며 오한과 빈뇨 혈뇨를 본다면 신우염을 의심해 본다고 합니다.
오늘은 신우염 증상 알아볼까 하는데요.

신우염 초기증상. 그러나 이러한 현상을 대부분이 노화로 인하여 혹은 활동량이 부족해서 아침마다 이러한 증상이 발현이 되는 것이라고 가볍게 생각 할 수 있다고 합니다. 그 탈출된 점막 때문에 항문주위가 가려운 증상이 생길 수 있습니다. 그렇기 때문에 임신 초기 증상은 되도록이면 빨리 알아차리는 것이 가장 중요한데요 임신을 계획 중이시라면 임신 초기.
다른 병도 그렇지만 간암도 초기에 발견해야 빠른 치료가 가능하고 완치율도 올라갑니다 이때문에 간암 초기증상에 관심을 드러내는 분들이 많은데요 대표적인 간암 초기증상에는 뭐가 있는지 한 번 알아보도록 하죠 간암 초기. 진행성 직장암의 가장 대표적인 증상으로는 대변에 피가 섞여 나오고 변비 또는 설사가 심해지는 등 눈에 띄는 배변 습관의 변화가 생깁니다. 신우염 증상 알아보면 나이별 대로 증상이 달리 나타날 수 있다고 하는데요.
병이 진행되면서 배변 시에 돌기가 항문 밖으로 나왔다가 들어가고 항상 나와있기도 합니다. 초기 당뇨병 신장 병증은 증상이 거의 없지만 말기에 가면 증상이 발생하여 신장부전에 의한 소변 내 고단백 배출이 일어날 수 있습니다. 하지만 팔꿈치나 무릎 혹은 귓바퀴 등 전혀 예상하지 못하는 부위에도 증상이 나타날 수 있으니 잘 살펴보시기 바랍니다.
간암 초기증상 뭐가 있나. 임신 초기 증상은 개인별 차이가 있겠지만 거의 자각을 못 하는 경우가 많습니다. 두번째로는 발가락 부위 중 엄지 발가락 부위가 많이 붓는 경우 통풍을.
이 외에 열감이 느껴지거나 심한 경우 혈뇨를 보고 소변양이 줄어들기도 합니다. 폐암의 증상 01 기침. 간단하게 설명을 드리자면 아침에 일어나서 손을 깍지를 꼈을 때 평상시보다 좀 뻑뻑하다고 생각하시면 부정이.
신장 신우염 증상. - 허리가 쑤시고 통증이 있다. 그 첫 번째는 부종입니다.
신장이 안좋으면 흔히 발생하는 증상 초기 증상 신장이 안 좋아졌을 때 흔하게 나타날 수 있는 증상들을 몇 가지 말씀드리도록 하겠습니다. 신장염 초기증상은 피곤하고 무력감을 느끼며 옆구리나 허리가 아프고 얼굴이나 몸이 붓는다는 것입니다. 내치핵의 가장 흔한 증상은 출혈이며 내치핵은 초기에는 배변시의 출혈은 있어도 통증은 없지만.
어떤 증상이 나타났을 때는 안타깝게도 이미 직장암이 상당히 진행되었을 가능성이 큰데요. 참고로 오전부터 속 위장 이 평소보다는 많이 불편했습니다. 백내장의 초기증상 8가지만 기억하시면 됩니다.
또한 증상이 나타나기 전 초기 증상인 전조증상이 나타나기도 하는데 이때는 분노 불안 우울 체계적이지 못하거나 사회성 저하 등이 나타나기도 합니다. 피섞인 가래나 피를 토하는 것 즉 객혈 역시 폐암의 중요한 증상 중 하나인데 폐로부터의 출혈은 가래와 섞여 있고 붉은 빛으로. 해당 조조강직 증상이 나타난다는 것은 관절염의 대표적인 초기 증상으로 자주 발현이 된다고 합니다.
소아는 발열 식욕부진 구토 경련이 동반되고. 오한 고열 두통 동반 증상은 가끔씩 초여름에 한 번씩 있었기에. 협심증은 심장으로 가는 동맥 혈관이 붓거나 지방이나 찌꺼.
그럼 지금부터 기관지 혹은 폐와 연관된 증상은 어떤 것이 있는지 함께 알아보도록 하겠습니다. 피부에 증상이 나타나기전 수두 초기증상은 약 12일 전에 열이나는 것입니다. 지난 수요일 오후부터 오한이 나더니 40 도 가까이 고열이 발생했습니다.
대변이 가늘어지기도 하고 배변 후에도 대변을 시원하게 보지 못한 잔변감이 있기도 합니다. 협심증 초기증상 혈관질환에서 가장 빈번히 찾아오고 많은 혈관질환의 합병증의 원인이 되기도 하는 합병증에 대해 여러분들도 많이 들어보셨을 텐데요. 노인성 안질환인 백내장은 대부분 나이가 들면 발병하는 경우가 많은데 노안과 그 증상이 비슷해 환자 입장에서는 구별이 쉽지 않은 안구 질환이라 할 수 있습니다.
허리디스크 초기 증상 - 누워서 다리를 들어 올리면 많이 올라가지 않는다. 특히 12주 차에는 뚜렷한 신체 변화가 없기 때문에 더더욱 모르고 지나갈 수 있죠. 이런 증상 있다면 통풍초기증상 의심.
- 기침이나 재채기를 하면 허리 통증이 있다. By 압구정안과의원 압구정안과의원 2021. - 엉덩이와 다리가 아프고 저리다.
남들은 잘 몰라도 본인은 아주 민감하게 알 수 있는 증상이 바로 이 부종인데요. 첫째 손가락과 손등 발가락 발목 등 주로 발끝 손끝 관절 부위의 통증을 들 수 있습니다. 폐암의 증상 02 객혈.
그때부터 초기증상 시작으로 보고 510일까지 딱지가 나고 가라앉을 때 까지를 수두 전염성이 있는 시기라 보고 있습니다. 팽창 보통 아침에 눈 주위에 일어납니다. - 누우면 허리 통증이 사라진다.
통풍 초기증상 첫 번째로 팔꿈치 무릎 등 관절 통증이 자주 나타나는 경우 통풍을 의심 해볼 수 있습니다.

급성 만성 신우신염 증상 발열 고열 옆꾸리 통증 원인 치료에 대해 알아봅시다

급성 만성 신우신염 증상 발열 고열 옆꾸리 통증 원인 치료에 대해 알아봅시다

신장염 신우염 신장염의 원인과 증상에 대해 알아보아요 네이버 블로그
급성신우신염 의 증상과 원인 진단과 치료 방법 항생제 치료

고열에 옆구리 통증 신우신염 여름철 급증 Ytn Youtube

급성 신우신염의 모든것 증상과 치료 예방 신우염에좋은음식 네이버 블로그